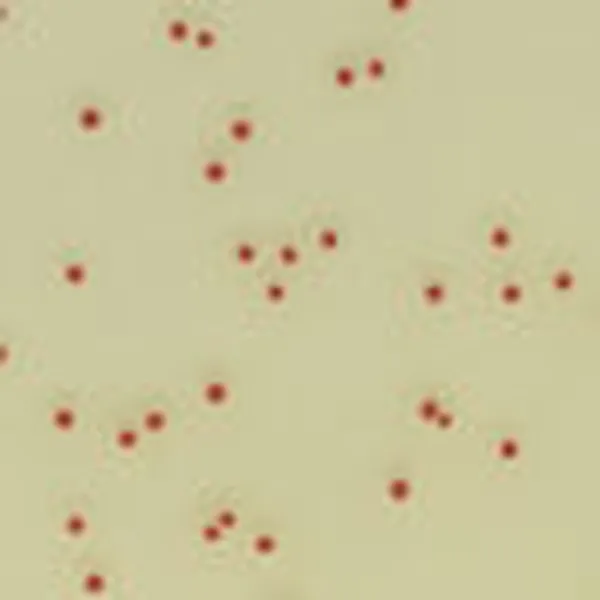
CHROMagar™ Campylobacter
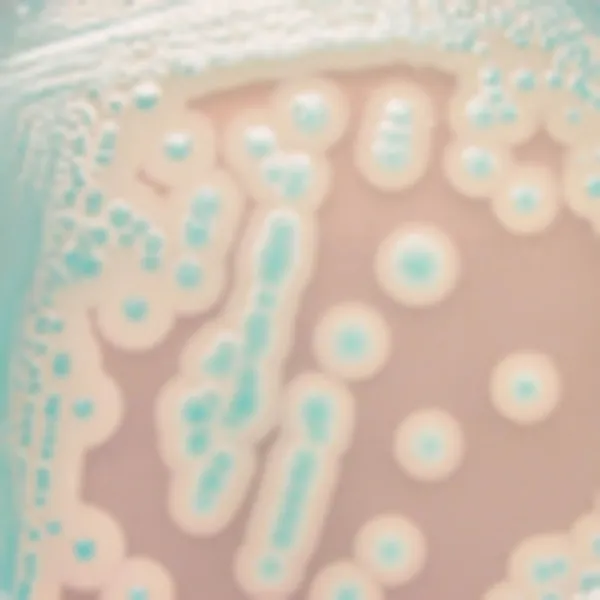
CHROMagar™ B. cereus

Hình thái khuẩn lạc

Pathogenic Y. enterocolitica
Màu tím hoa cà

Non pathogenic Y. enterocolitica và vi hệ nền (Citrobacter, Enterobacter, Aeromonas v.v.)
Màu xanh kim loại, bị ức chế hoặc tăng trưởng hạn chế với màu xanh kim loại
Hiệu năng
Hiệu năng
Trong chi Yersinia, Yersinia enterocolitica là một trong những tác nhân gây bệnh truyền qua thực phẩm phổ biến nhất. Tại một số quốc gia, Y. enterocolitica đã vượt Shigella và gần đến mức Salmonella và Campylobacter như nguyên nhân chủ yếu gây viêm dạ dày ruột do vi khuẩn cấp tính. Khả năng phát triển ở nhiệt độ lạnh của nó làm tăng mối quan ngại về an toàn thực phẩm. Vi khuẩn này thường ảnh hưởng đến những người trẻ tuổi. Tuy nhiên, chỉ một vài chủng Y. enterocolitica gây bệnh cho người. Những chủng gây bệnh thuộc về các kiểu sinh học 1B, 2, 3, 4 và 5, trong khi kiểu sinh học 1A không gây bệnh và phổ biến trong môi trường. Heo là nguồn chủ yếu mang Y. enterocolitica gây bệnh.
Mục đích sử dụng :
CHROMagar™ Y.enterocolitica là môi trường nuôi cấy chromogen chọn lọc dùng để phát hiện định tính trực tiếp, phân biệt và nhận dạng sơ bộ các kiểu sinh học gây bệnh của Yersinia enterocolitica. Xét nghiệm được thực hiện với mẫu gạc trực tràng và phân, nhằm hỗ trợ chẩn đoán nhiễm Y. enterocolitica. Kết quả có thể được giải thích sau 36-48 giờ ủ hiếu khí ở 30 °C ± 2 °C.
Các nuôi cấy đồng thời là cần thiết để phục hồi vi sinh vật cho các xét nghiệm vi sinh học hoặc đánh giá dịch tễ học. Thiếu tăng trưởng hoặc không xuất hiện khuẩn lạc trên CHROMagar™ Y.enterocolitica không loại trừ sự hiện diện của Y. enterocolitica. CHROMagar™ Y.enterocolitica không nhằm mục đích chẩn đoán nhiễm trùng, không hướng dẫn hay theo dõi điều trị nhiễm trùng. CHROMagar™ Y.enterocolitica cũng có thể được sử dụng trong việc phát hiện Y. enterocolitica trong phân tích sản phẩm thực phẩm cho con người, thức ăn gia súc và mẫu môi trường.
Thành phần

Tài liệu kỹ thuật
Công bố khoa học
2018
Jämförelse av CIN-agar och CHROMagar™ Y. enterocolitica vid identifiering av humanpatogena Yersinia enterocolitica
📄 Publication2013
Comparison of CHROMagar Yersinia and CIN Agar media for isolation of potentially virulent Yersinia enterocolitica in stools
📄 Publication2013
Differentiation of Yersenia enterocolitica biotype 1A from pathogenic Yersenia enterocolitica biotypes by detection of B-glucosidase activity: comparison of two chromogenic culture media and Vitek2
📄 Publication2012
Comparison of CHROMagar Yersinia and CIN Agar media for isolation of potentially virulent Yersinia enterocolitica in stools
📄 Publication

Xem thêm